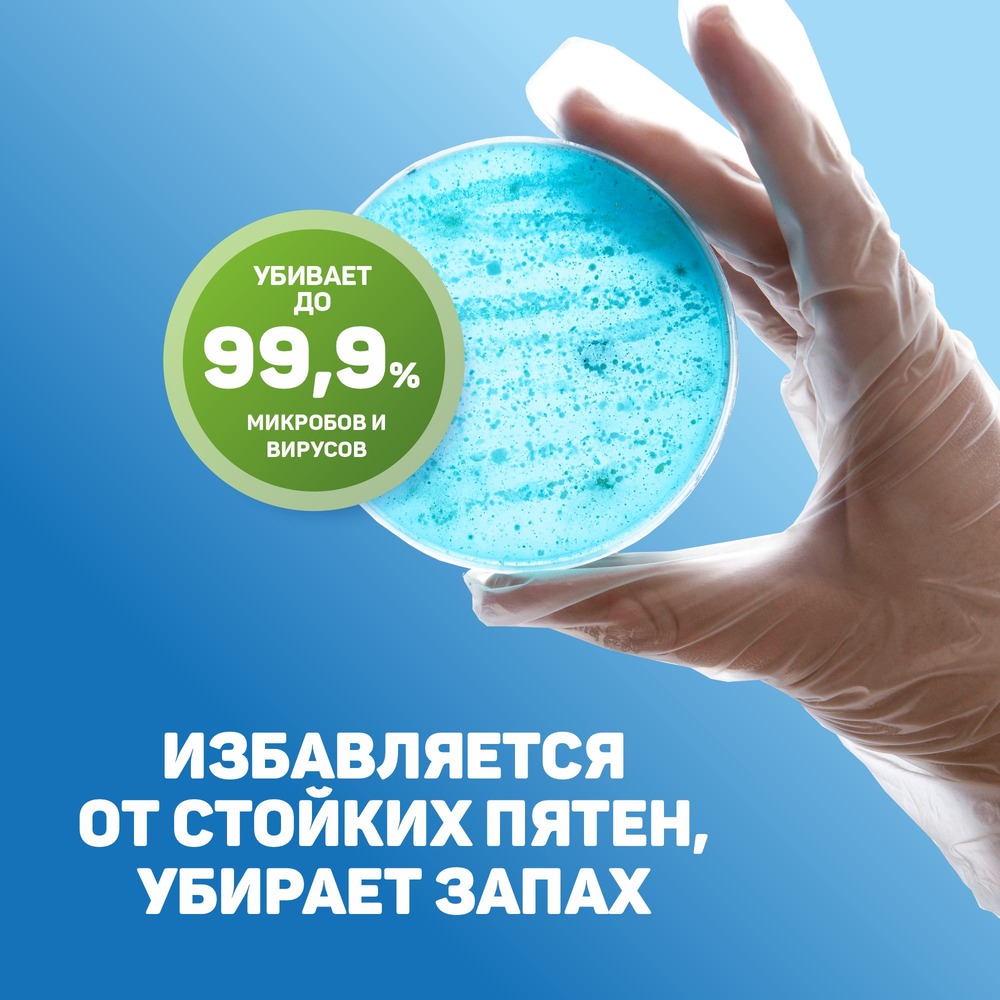

Keon гель д/стирки 1,38л д/в тип.бел. лаванда дозатор 1шт / 8шт / R040901067 / 223406
Подробности
664.05 ₽
699 ₽
-5%
Экономия
34.95 ₽
Есть в наличии: 26 в 1 магазине
В корзину
Можно забрать сегодня или когда удобно*
СМС, когда заказ соберут для Вас
Без предоплаты. Оплата в магазине
СМС, когда заказ соберут для Вас
Без предоплаты. Оплата в магазине
Характеристики
Тип
—
гель
Тип тканей
—
все типы, кроме шерсти и шелка
Назначение
—
универсальное
Особенности
—
без хлора, с солью
Аромат
—
лаванда, цветочный
Объем, л.
—
1.38
Все характеристики
Внешний вид товара может отличаться от фотографий, представленных в интернет-магазине.
Жидкое ЭКО мыло для стирки (гель) KEON, с ароматом лаванды 1,38 л в Санвэй.
- Экологически безопасное средство для стирки, эффективно и бережно отстирывает различные загрязнения на одежде и белье, придает мягкость и нежный аромат вещам после стирки.
- Подходит для стирки хлопка, льна и синтетических тканей. Не подходит для стирки шелка и шерсти.
- Жидкое мыло заменяет 10 кусков обычного мыла для стирки.
- Подходит для автоматических стиральных машин любого типа и ручной стирки.
- Отстирывает и удаляет въевшиеся пятна даже в холодной воде.
- Легко выполаскивается.
- Мыло не содержит фосфатов, имеет легкий, свежий аромат лаванды.
Состав продукта:
Поверхностно-активное вещество 40%, Aes 25% Синергетический эффект обеззараживания 15%, Натуральная соль 10%, компонент для быстрого ополаскивания 8%, отдушка лилия 2%.
Способ применения:
Похдодит для тканей из хлопка, льна, всех видов искусственных тканей и тканей смешанного типа. Не подходит для стирки шелка и шерсти.
Для ручной стирки использовать 1 мерную ложку (20г) на 2-3кг белья.
Для машинной стирки использовать 20г жидкого порошка на 2-3 кг белья., 40г жидкого порошка на 4-5 кг белья
Тип
гель
Тип тканей
все типы, кроме шерсти и шелка
Назначение
универсальное
Особенности
без хлора, с солью
Аромат
лаванда, цветочный
Объем, л.
1.38
Вид стирки
автоматическая, ручная
Отзывы
Оставить отзыв
Загрузка отзывов...
С этим товаром покупают